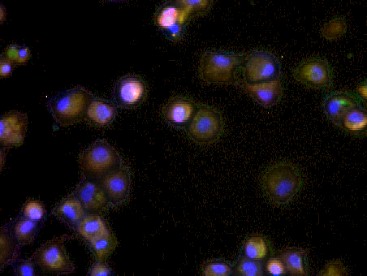
HBcAg Rabbit pAb(bs-15455R)-50

HepG2-NTCP HBV infected; 4% Paraformaldehyde-fixed; Triton X-100 at room temperature for 20 min; Blocking buffer (normal goat serum) at 37°C for 20 min; Antibody incubation with (HBcAg) Polyclonal Antibody, Unconjugated (bs-15455R) 1:100, 90 minutes at 37°C; followed by a conjugated Goat Anti-Rabbit IgG antibody (AF488,1:200) at 37°C for 90 minutes, DAPI (blue)was used to stain the cell nuclei.
Maria Francesca Cortese,PhD researcher in Vall d'Hebron Research Institute (VHIR) of Barcelona (Spain).
相关产品推荐更多 >
万千商家帮你免费找货
0 人在求购买到急需产品
- 详细信息
- 文献和实验
- 技术资料
- 应用范围:
产品信息以Bioss网站为准
- 规格:
50ul/100ul/200ul
| 规格: | 50ul | 产品价格: | ¥1180.0 |
|---|---|---|---|
| 规格: | 100ul | 产品价格: | ¥1980.0 |
| 规格: | 200ul | 产品价格: | ¥2800.0 |
| 产品编号 | bs-15455R |
| 英文名称 | HBcAg Rabbit pAb |
| 中文名称 | 乙肝病毒衣壳蛋白抗体 |
| 英文别名 | C; Capsid protein; Core and e antigen; Core antigen; Core antigen; Core protein; HBc; HBcAg; HBVgp4; Hepatitis B Virus core antigen; p21.5; precore/core protein; CAPSD_HBVA3. |
| 产品应用 | ICC/IF=1:50-200 Not yet tested in other applications. |
| 交叉反应 | (Hepatitis B virus) |
| 抗体来源 | Rabbit |
| 免疫原 | KLH conjugated synthetic peptide derived from Hepatitis B Virus Core Antigen |
| 亚型 | IgG |
| 性状 | Liquid |
| 纯化方法 | affinity purified by Protein A |
| 克隆类型 | Polyclonal |
| 理论分子量 | 21 kDa |
| 浓度 | 1mg/ml |
| 储存液 | 0.01M TBS (pH7.4) with 1% BSA, 0.02% Proclin300 and 50% Glycerol. |
| 研究领域 | Microbiology > Organism > Virus > DNA Virus > double stranded DNA Virus > Hepatitis B |
| 亚基 | Li-HBsAg interacts with capsid protein and with HDV Large delta antigen. Isoform M associates with host chaperone CANX through its pre-S2 N glycan. This association may be essential for M proper secretion. |
| 亚细胞定位 | Virion membrane. |
| 翻译后修饰 | Isoform M is N-terminaly acetylated at a ratio of 90%, and N-glycosylated at the pre-S2 region.
Myristoylated. |
| 相似性 | Belongs to the orthohepadnavirus major surface antigen family. |
| 功能 | The large envelope protein exists in two topological conformations, one which is termed 'external' or Le-HBsAg and the other 'internal' or Li-HBsAg. In its external conformation the protein attaches the virus to cell receptors and thereby initiating infection. This interaction determines the species specificity and liver tropism. This attachment induces virion internalization predominantly through caveolin-mediated endocytosis. The large envelope protein also assumes fusion between virion membrane and endosomal membrane (Probable). In its internal conformation the protein plays a role in virion morphogenesis and mediates the contact with the nucleocapsid like a matrix protein.
The middle envelope protein plays an important role in the budding of the virion. It is involved in the induction of budding in a nucleocapsid independent way. In this process the majority of envelope proteins bud to form subviral lipoprotein particles of 22 nm of diameter that do not contain a nucleocapsid. |
| 保存条件 | Shipped at 4℃. Store at -20℃ for one year. Avoid repeated freeze/thaw cycles. |
| 注意事项 | This product as supplied is intended for research use only, not for use in human, therapeutic or diagnostic applications. |
| 背景资料 |
| 应用 | 推荐稀释比例 |
| {ICC/IF} | {1:50-200} |
风险提示:丁香通仅作为第三方平台,为商家信息发布提供平台空间。用户咨询产品时请注意保护个人信息及财产安全,合理判断,谨慎选购商品,商家和用户对交易行为负责。对于医疗器械类产品,请先查证核实企业经营资质和医疗器械产品注册证情况。
文献和实验该产品被引用文献
[IF={{ 34.9 }}] {Yi Yakun. et al. Nanopore-based enzyme-linked immunosorbent assay for cancer biomarker detection. NAT NANOTECHNOL. 2025 May;:1-8} {ELISA} {Human}
技术资料暂无技术资料 索取技术资料
文献支持
HBcAg Rabbit pAb(bs-15455R)-50ul/100ul/200ul
¥1180 - 2800









